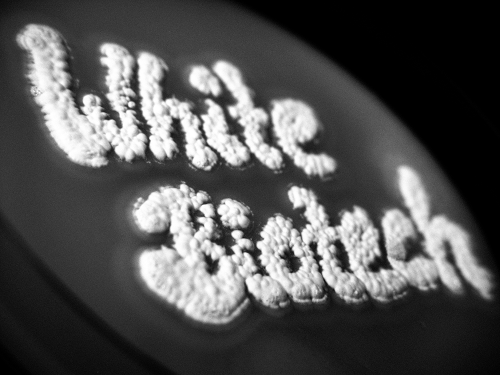

[뉴스비전e 김혜진 기자] 최근 지구 온난화로 인해 이상기온이 발생하는 등 피해가 잇따르면서 환경에 대한 관심이 높아지고 있다.
전세계 196개국이 '파리 기후변화 협약'에 가입하는 등 이산화탄소 배출을 줄이기 위해 노력하고 있는 가운데, 기존의 화석연료 기반 화학제품인 화학소재, 연료 등을 바이오공정으로 생산하는 화이트바이오 기술이 부각되고 있다.
OECD는 오는 2030년이면 바이오산업이 IT에 버금가는 규모가 될 것이라고 내다보고 있다.
건강 · 식량 · 환경 등 인류의 중요한 난제들을 해결할 수 있는 미래 경제의 핵심 산업으로 성장하고 있는 화이트 바이오에 대해 심층 분석해 본다. [편집자 주]

[④ 화이트바이오 육성 및 원천기술 확보 위한 정부 지원 '시급' ]
우리나라의 바이오 분야 전체 정부R&D 예산은 지난해 1.9조원을 돌파했지만 레드바이오(의약)와 그린바이오(농업) 분야가 대부분의 예산을 차지하고 있는 상황이다.
화이트바이오 분야 정부R&D 예산은 872억 원에 불과한 수준이다.
바이오화학산업화촉진기술개발사업(산업부), C1가스리파이너리사업(과기정통부) 등의 신규
추진으로 매년 예산이 평균 13.4%씩 증가했지만, 아직 분야에 비해 투자가 미약한 상태다.
2017년 기준 바이오 분야 정부R&D 투자액 중 레드바이오 49.1%, 그린바이오 46.4%에 비해 화이트바이오는 4.5% 수준에 그치고 있다.
또한 바이오화학 육성전략 발표 이후 관련 R&D 사업 및 인프라 구축이 추진됐으나, 바이오제품 인증, 의무구매제도 등 판매 촉진을 위한 제도 도입은 거의 없는 상태다.
현재 의무혼합제도(RFS) 비율은 2.5%로 EU(10%), 브라질(5~25%) 등 타 국가에 비해 낮은 수준이며, 바이오제품 인증제도는 바이오플라스틱에 한정되어 운영되고 있다.
현재 과기정통부와 산업부를 중심으로 바이오연료 위주(68.8%)의 투자가 이루어지고 있으며, 바이오매스 유래 소재 분야는 산업부와 해수부를 중심으로 투자되고 있다.
바이오연료 분야의 경우 과기정통부와 해수부는 대학, 출연연 중심의 원천기술개발 대형사업단 중심으로 R&D를 추진하고 있으며, 산업부는 기업 중심의 상용화 기술개발 과제를 추진하고 있다.
바이오매스 유래 소재 분야는 산업부와 해수부 중심으로 상용화 대량생산 기술개발 및 원천기술 확보에 일부 투자되고 있다.
현장에서 연구개발을 추진하고 있는 기업들은 정부의 체계적인 지원이 시급하다고 지적하고 있다.
한국과학기술평가원이 화이트바이오 산업에 종사하고 있는 32개 기업을 대상으로 설물조사를 펼친 결과, 응답기업중 66%가 '국내외 기술격차가 크다'고 답했으며, 97%가 화이트바이오 산업의 기술개발이 시급하다고 느끼고 있는 것으로 나타났다.
또한 기술격차 해소를 위해 가장 필요한 것을 묻는 질문엔 35%가 '기술력 확보', 30%는 '정부지원 확대가 필요하다'라고 답했다.
한국과학기술평가원은 "화이트바이오 산업 육성을 위해선 세제 지원 등 금전적 지원과 의무구매 제도 등 정부의 제도적 지원이 필요하다"며 "중소 · 벤처기업을 위해선 생산라인(제조시스템) 구축 및 인력양성에 초점을 맞추고, 대기업 · 중견기업을 위해서는 관련 법규나 생물자원 인프라의 강화에 초점을 맞춰야 한다"고 분석했다.
